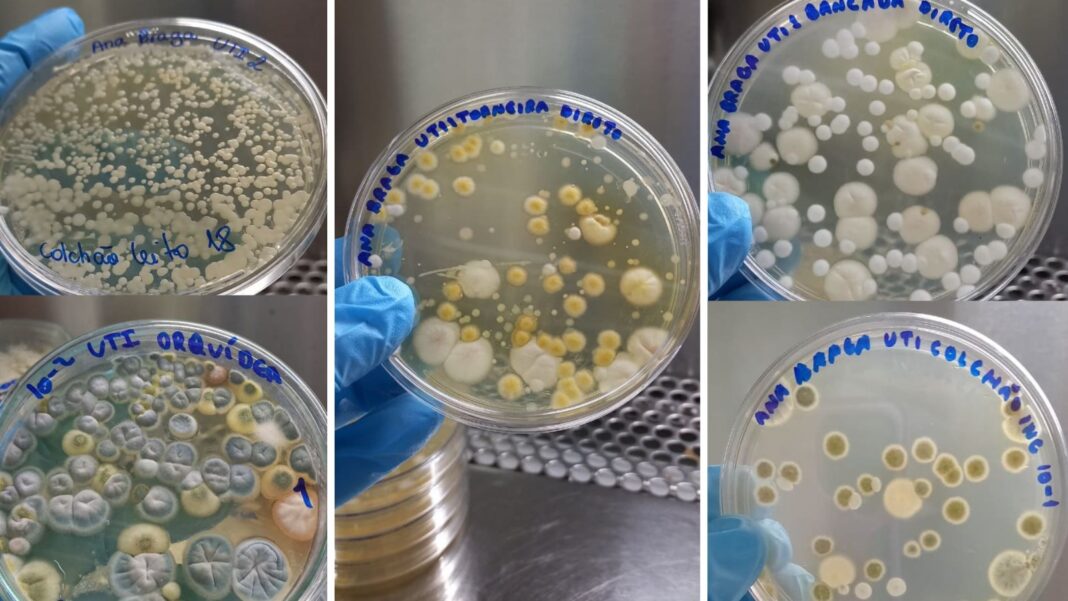

Realizar a vigilância epidemiológica das espécies de cândida em efluentes clínicos (rede de esgoto hospitalar) e avaliar a carga fúngica em um hospital de Manaus foram os principais objetivos de uma pesquisa apoiada pelo Governo do Amazonas, por meio da Fundação de Amparo à Pesquisa do Estado do Amazonas (Fapeam), realizada no âmbito do Programa de Apoio à Iniciação Científica (Paic).
A pesquisa conquistou o 1º lugar na 10ª Jornada Científica da Fundação de Vigilância em Saúde do Amazonas – Dra. Rosemary Costa Pinto (FVS-RCP). Intitulado “Vigilância Epidemiológica de espécie de cândida em efluentes clínicos: avaliação da carga fúngica em um hospital da cidade de Manaus”, o estudo foi desenvolvido pela estudante Patrícia dos Santos Souza, graduanda do curso de Farmácia, sob orientação do doutor em Biodiversidade e Biotecnologia e pesquisador Walter Oliva Pinto Filho, e coorientação da biomédica e mestre em ciências farmacêuticas, Vanessa de Sá Pinheiro, ambos da FVS-RCP.
Segundo a pesquisadora a proposta foi compreender como esses microrganismos circulam nesse ambiente e identificar possíveis riscos relacionados à resistência antifúngica. O estudo tem contribuição social relevante, pois ajuda a compreender como a cândida circula em ambientes hospitalares e em efluentes, o que poderá auxiliar na prevenção de surtos, no controle de infecções e até orientar políticas públicas relacionadas ao manejo e tratamento desses resíduos, além do que os resultados podem impactar diretamente no controle de infecções hospitalares e na qualidade de vida da população.
Coleta e análise
Durante a pesquisa, foram coletadas amostras no esgoto do hospital, seguido do isolamento e identificação das leveduras com equipamentos de rotina em microbiologia, como microscópio, pipetas, autoclave, estufas de incubação e meios de cultura, que possibilitaram o isolamento e a manutenção das amostras.
Para a caracterização das espécies de cândida, foram aplicados o microcultivo, que permite observar as estruturas do fungo, e o auxonograma, utilizado para avaliar a assimilação de diferentes açúcares. Os resultados foram analisados quanto à frequência das espécies de cândida e à carga fúngica presente nos diferentes pontos de coleta e revelaram elevada carga fúngica no efluente bruto, com predominância de Cândida albicans, seguida por espécies não albicans, como C. tropicalis e C. parapsilosis.
Cepas resistentes em ambientes hospitalares
A pesquisadora destaca que algumas espécies de cândida são reconhecidas pela resistência antifúngica em ambiente hospitalar. Os efluentes podem funcionar como rota de disseminação dessas cepas para o meio externo, representando risco para a saúde pública.
“Já foram observados indícios de resistência a determinados antifúngicos utilizados na prática clínica, o que reforça a necessidade de monitoramento constante”, disse Patrícia dos Santos.
Esses microrganismos podem chegar ao meio ambiente, atingir a comunidade e até retornar ao ambiente hospitalar, perpetuando um ciclo de contaminação.
“Ao revelar a presença de cândida resistente nos efluentes, a pesquisa fornece dados que podem subsidiar melhorias no tratamento de resíduos hospitalares e auxiliar na elaboração de medidas preventivas para a cidade”, explica a pesquisadora.
A longo prazo, a expectativa é de que a pesquisa abra espaço para outros estudos na área, contribuindo para a criação de protocolos de monitoramento e fortaleça medidas de controle mais eficazes contra a resistência antifúngica.
Fomento à pesquisa
A pesquisadora Patrícia dos Santos destacou a importância da Fapeam no fomento de pesquisas voltadas para a área da saúde.
“O apoio da Fapeam foi muito importante para mim, porque a bolsa me deu condições de continuar na pesquisa com mais tranquilidade. Graças a esse incentivo, consegui me dedicar melhor ao projeto e desenvolver o trabalho de forma mais organizada, o que fez bastante diferença nos resultados”, comentou.
Sobre o Paic
O Paic/Fapeam contribui de forma significativa para o fortalecimento da pesquisa científica no Amazonas, oferecendo bolsas e oportunidades para que estudantes de graduação participem ativamente de projetos desenvolvidos em instituições de ensino e pesquisa, promovendo a formação de novos talentos, geração de conhecimento e avanço da ciência na região.